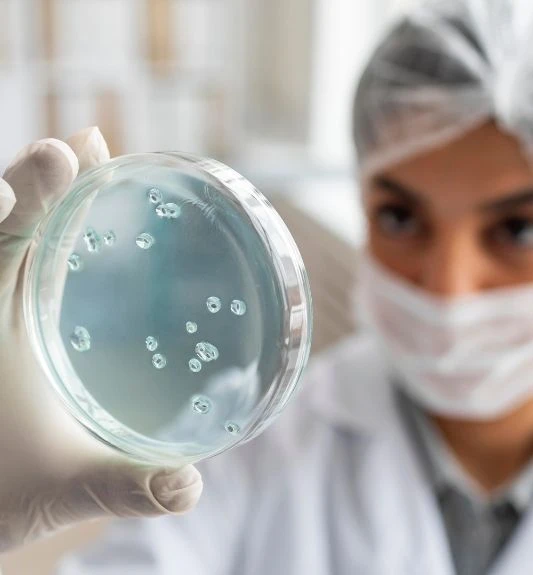

Allergies
ALLERGIES


Symptoms, Diagnosis, Treatment and Management
Allergies are among the most common chronic conditions worldwide. Allergy symptoms range from making you miserable to putting you at risk for life-threatening reactions.
According to the leading experts in allergy, an allergic reaction begins in the immune system. Our immune system protects us from invading organisms that can cause illness. If you have an allergy, your immune system mistakes an otherwise harmless substance as an invader. This substance is called an allergen. The immune system overreacts to the allergen by producing Immunoglobulin E (IgE) antibodies. These antibodies travel to cells that release histamine and other chemicals, causing an allergic reaction. Here at Tapia Internal Medicine Clinic PLLC we offer allergy consults, testing and immunotherapy.
When is Allergy Testing Appropriate?
Testing done by a doctor is generally safe and effective for adults of all ages. The allergen extracts or vaccines used in allergy tests performed by us meet U.S. Food and Drug Administration (FDA) requirements.
Symptoms which usually prompt an allergist to perform testing include:
- Respiratory: itchy eyes, nose or throat; nasal congestion, runny nose, watery eyes, chest congestion, cough or wheezing
- Skin: itchiness or eczema
- Abdominal: vomiting or cramping and diarrhea consistently after eating certain foods
- Severe reactions to stinging insect stings (other than swelling at the site of the sting)
- Anaphylaxis (pronounced an-a-fi-LAK-sis): a serious allergic reaction that affects many parts of the body at the same time.
It is important that allergy testing is directed by a healthcare professional with sufficient allergy/immunology training and prompted by your medical history.
Types of Allergy Tests
Different allergens bother different people, so your allergist will determine which test is the best for you. Regardless of the type of test, an allergist will first perform a physical examination and ask questions about your symptoms to determine if allergy testing is warranted.

IgE Skin Tests
This type of testing is the most common and is relatively painless. A very small amount of certain allergens is put into your skin by making a small indentation or “prick” on the surface of your skin.
If you have allergies, just a little swelling that looks and feels like a mosquito bite will occur where the allergen(s) to which you are allergic was introduced. If you are allergic to ragweed pollen but not to cats, only the ragweed allergen will cause a little swelling or itching. The spot where the cat allergen was applied will remain normal.
You don’t have to wait long to find out what is triggering your allergies. Reactions occur within about 20 minutes. And you generally won’t have any other symptoms besides the small hives where the tests were done, which go away within 30 minutes. If your prick skin tests are negative but your physician still suspects you might have allergies, more sensitive “intradermal” tests may be used in which a small amount of allergen is injected within Skin tests are best performed in an allergist’s office to assure the test results are read properly and to minimize the risk of rare side effects.
Treatments available at Tapia Clinic
Allergy Skin Testing
Allergy skin testing is an in-office procedure used to identify specific allergens that may be causing your symptoms. A small amount of common North East Texas allergens is placed on the skin using a gentle prick method. If you’re sensitive to any of these allergens, a small raised bump may appear at the test site. The results help your provider determine which environmental triggers are contributing to your reactions and guide your treatment plan.
Immunotherapy (Allergy Shots)
Allergen immunotherapy is a long-term treatment designed to help reduce your sensitivity to the allergens identified during testing. Based on your skin-test results, a customized blend of allergens is prepared for you. Small, gradually increasing doses are administered in the clinic on a regular schedule. Over time, immunotherapy can help lessen the frequency and severity of allergic symptoms by training your immune system to respond less strongly to these triggers.
Breathe Easy, Live Allergy-Free!
We’re always happy to welcome new patients. Our commitment is to provide the best possible care to those we already serve while inviting new patients to experience the same high standard of service.
903-739-7920

Immunotherapy
Anyone who has lived in the North Texas area has experienced allergies at some point in their lives. Our area has amongst the highest pollen counts in the nation. Patients with allergies constantly suffer from sneezing, runny nose, watery eyes and have multiple ear, sinus and bronchial infections.
Treatment for seasonal and perennial allergies consist of continuous use of several antihistamines, steroid nasal sprays and inhalers. However these medications give limited relief for the most part, and there is also significant fatigue having to take these medications continuously.
Allergen immunotherapy , also called allergy shots, comes to the rescue in this situation. Immunotherapy is a preventive treatment for allergies from environmental agents such as pollen, grasses, trees, mold and dust mites. Allergy shots make the immune system to be less sensitive to these environmental agents, and they reduce inflammation in the respiratory tract that causes allergy symptoms.
Tapia Internal Medicine Clinic is now offering a full scale of Allergy skin testing and Allergen Immunotherapy to our area where these options are limited but very needed.

The Allergen Immunotherapy program consists of the following steps.
First an allergy prick test is performed in the office. We test you for multiple different allergens that are common in our North East Texas area
Based on the results of the allergy test a customized blend of allergens is created for you for immunotherapy.
We verify your insurance coverage before we do the test
Cash payment options are also available.
Immunotherapy can be given in
2 ways.
Subcutaneous Immunotherapy: In subcutaneous immunotherapy the allergen is administered in the form of allergy shots. Allergy shots are given with increasing amounts of allergens once a week to help your body become immune to the allergen. After about 3-6 months of therapy you will notice a significant decrease in your symptoms of allergies.Allergy shots are given in the doctor’s office so that we can monitor you for any adverse reactions.
Sublingual Immunotherapy: In sublingual immunotherapy the allergen is administered in the form of drops which are taken under the tongue. These are very well tolerated and offer the convenience of using them at home and not having to come to the office once a week. These are not covered by insurance, however are affordable pricing of just $20 a week makes it possible for patients to utilize this therapy.
FREQUENTLY ASKED QUESTIONS
We offer allergy skin testing and allergen immunotherapy (commonly called allergy shots) to identify what triggers your symptoms and help reduce your sensitivity over time.
If you experience repeated symptoms like itchy or watery eyes, nasal congestion, sneezing, rashes, or symptoms that get worse in certain environments, testing may help determine whether allergens are the cause.
Allergen immunotherapy involves receiving small, gradually increasing doses of the allergens you’re sensitive to (via injections or other methods) under medical supervision so your immune system becomes less reactive over time.
Yes. Over-the-counter or prescription antihistamines help manage symptoms but don’t address the underlying immune sensitivity. Testing and immunotherapy can offer a longer-term strategy when appropriate, in consultation with your provider.
It varies based on your sensitivity, allergens identified, and response. The initial build-up phase often involves more frequent visits, followed by a maintenance phase with less frequent visits. Your provider will explain what to expect.
Many insurance plans cover allergy testing and immunotherapy when medically indicated. Our staff will help check your coverage and explain any portions you may need to pay out-of-pocket.
Call our clinic at (903) 739-7920 to schedule a consultation. During your visit, we’ll review your symptoms, possibly order testing, and determine whether immunotherapy is a good fit for you.
As with any medical procedure, there can be mild reactions (e.g., local redness or itch where the injection was given). Because immunotherapy adjusts your immune system, close monitoring is provided to ensure safety. Your provider will review the risks and benefits with you.








